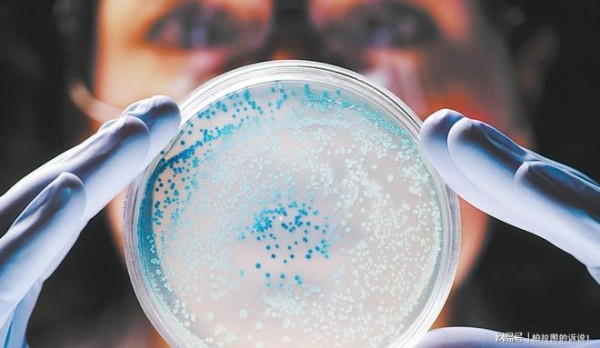

52岁女子,查出肝癌,厨房1物3个月不清洗,全家人的肝都遭殃
定期检查肝癌标志物,如乙型肝炎和丙型肝炎病毒。 #生活知识# #科技生活# #健康生活技巧# #癌症#

“你家的砧板多久没换了?”或许很多人会漫不经心地回答:“还能用,没坏就没换呗。”可你是否想过,仅因一个被忽视的厨房细节,竟可能让全家陷入健康危机?就在上个月,52岁的林阿姨突然被诊断出患有肝癌。她一向身体硬朗,家人惊疑不已。
医生细细回溯她的生活习惯,最终指向了厨房:一块用了3年、3个月未清洗的木质砧板。谁能想到,这个每日接触的“老物件”,竟成了暗藏在家里的健康“雷区”?林阿姨黯然叹息:“是不是一直忽视了什么?”

可事实远比她想象的更严重,这不是她一个人的问题,而可能影响到整个家庭的肝脏健康。看似普通的厨房砧板,真的会危及肝脏吗?背后到底藏着什么隐患?又该怎样科学规避,让健康不被厨房“拖后腿”?尤其是,这个“被忽视的细节”,你家是否也在悄然发生?
很多人认为,只要食材新鲜、烹饪卫生,就能守住饮食安全的底线。但实际上,中国营养学会曾指出,厨房砧板的卫生问题是家庭慢性疾病“高发源”之一。
一项涉及8000余户家庭的调查发现,超六成家庭的砧板表面存在可见霉斑和细菌滋生,尤其是木质砧板,表层和刀痕中更易藏污纳垢。

更可怕的是,肝癌的高风险因素之一,黄曲霉毒素,极易在潮湿、不易清理的厨房环境中滋生。木质砧板,正是黄曲霉菌温床。研究显示,在长期潮湿、污渍未彻底清洁的砧板表面,黄曲霉菌繁殖速度是普通瓷砖类厨具的2.4倍。而黄曲霉毒素B1是一类公认的强致癌物,即便极微量摄入也能增加肝癌风险。
有医生曾做过检测实验:一块3个月未清洗、长期未暴晒的木板,其表面黄曲霉毒素含量高达国家标准的7倍以上,严重威胁家人健康。
中国疾病预防控制中心调查发现,在我国南方潮湿省份,因砧板卫生问题诱发肝癌的比例近年来上升了近12%。大家都以为是饮食不洁、酒精损害导致肝癌,却忽视了厨房这个“头号污染源”。
很多家庭都共用一块砧板,殊不知,“共用污染源”比“饮食交叉”更可怕。坚持使用未清洗的砧板3个月后,家人的肝脏可能出现以下3种变化:
黄曲霉毒素摄入超标。实验显示,长期“吃下”污染食材,人体肝细胞的DNA损伤概率提高24.8%,肝脏解毒系统负担加重。
肝炎患病率增加。公开数据显示,和经常高温消毒砧板的家庭相比,不清洗砧板的家庭成员ALT(谷丙转氨酶)升高率高出17.3%。不少人出现肝区不适、食欲减退、易疲劳等“早期信号”,但往往被忽视。
肝癌风险骤增。中华医学会肝病学分会指出,华南某市肝癌住院患者中,约六成母亲为家庭厨师,逾半数家庭厨房存在长期未更换砧板的问题。其中有33.6%的病例,检测食材发现黄曲霉素超标。

林阿姨一家的遭遇,正是许多家庭疏于防范的真实缩影。让人警醒的是,肝脏自修复能力极强,但长期暴露于风险因素下,往往等到出现临床症状已近晚期。
如何安全用砧板?医生建议,这三招务必坚持,医生直言:“厨房卫生,砧板是头号重点。”只要养成3个好习惯,就能极大降低家庭肝癌等慢性病风险。
诀窍一:一生熟分开用,多板专用。
最好准备两块以上砧板,生肉与熟食、果蔬分开处理,减少交叉污染。美国FDA建议,每用毕立即用热水冲洗、晾干、定期暴晒。
诀窍二:定期高温消毒,彻底去除霉菌。
木质砧板建议每周用沸水浇烫一次,定时曝晒紫外线直射下不少于2小时。如果发现表面有难清除斑点、异味或明显刀痕,请及时更换。

诀窍三:保障厨房通风,建立“潮湿警报”。
保持厨房干爽,定期打开窗户,防止潮湿环境滋养霉菌。中国烹饪协会建议,南方潮湿季节可将砧板竖放、贴近通风口。
除此之外,还可以选用抗菌材质或食品级塑料砧板,相对更易清洗,但高温消毒不可省略。毕竟,健康的生活无小事,任何一点忽视都可能“乘虚而入”。
厨房细节,关乎全家人的幸福底线。科学证据早已反复证明,不洁砧板的隐患可能引发肝癌、肝炎等严重健康威胁。厨房卫生人人重视,但“老砧板”真的不能心存侥幸,别等悲剧发生才后悔。
网址:52岁女子,查出肝癌,厨房1物3个月不清洗,全家人的肝都遭殃 https://www.yuejiaxmz.com/news/view/1430023
相关内容
肝占位=肝癌 肝脏超声检查应该知道这些春天养肝=养命!晨起1不喝、吃饭2不省、睡前3不比,养出不老肝、想不长寿都难
癌症不是命运!这份致癌物“黑名单”就藏在你家厨房,速查避雷!
45岁前患脂肪肝 癌症风险升高 建议做好这4点→
全国爱肝日丨大多数肝癌发现就是晚期,养肝=养命
肝不好的5个标准 春季如何学会养肝护肝
救命!这5种‘毒餐具’正在腐蚀你的肝!家家厨房都有第4种!
肝癌有哪些症状
厨房里这些东西最伤肝!远离肝病做好3件事
中晚期肝癌=绝症?

